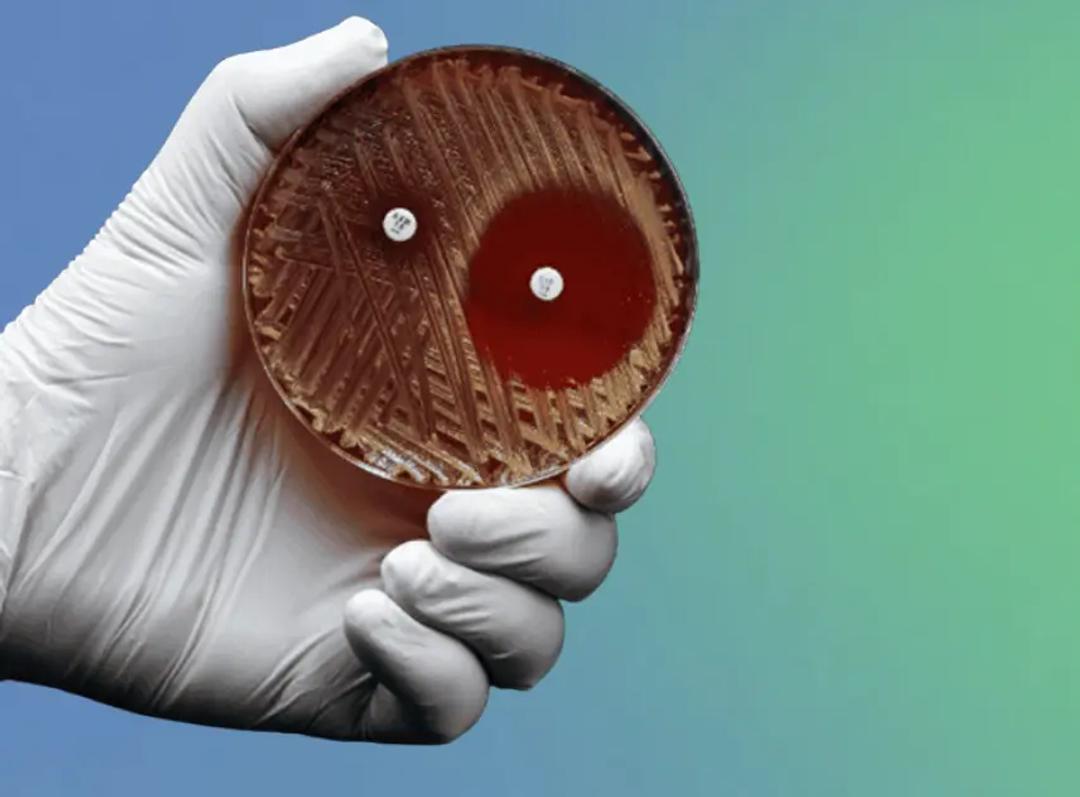
Antimicrobial resistance and the MRSA crisis

Infectious disease diagnostics and AMR
Discover the latest tools and technology powering the fight against infectious diseases and antimicrobial resistance
As the global burden of infectious diseases rises and antimicrobial resistance (AMR) threatens to outpace therapeutic advances, the need for rapid, precise, and scalable diagnostic solutions has never been more urgent. This feature explores the latest breakthroughs in infectious disease diagnostics—from rapid antimicrobial testing (AST) to nanopore sequencing and quality control. With a focus on the tools empowering today’s microbiology labs, we highlight how emerging technologies are transforming pathogen detection, resistance profiling, and ultimately, patient outcomes.

As we face narrowing treatment options for microbials, the challenge is no longer just identifying viable antibiotics but ensuring precise antimicrobial susceptibility testing (AST) to guide informed choices. Find out how.
Download resource
Discover comprehensive and easy-to-use, MDx-Chex controls evaluate the entire assay process, from cell lysis, DNA extraction and purification to nucleic acid detection and analysis.
Watch now
Explore a study that compares multiple bioinformatics approaches for taxonomic classification against known species and Sanger sequencing, providing clear insights into performance and accuracy.
Download resource
AMR is no longer a looming threat—it's a present-day crisis. Explore MRSA and the escalating crisis of antimicrobial resistance—demanding faster diagnostics, renewed stewardship, and urgent global action.
Read more
Find an extensive portfolio of serological assays for detection of IgG and IgM antibodies against pathogens of VPDs, as well as PCR-based assays for direct detection of selected parameters.
Read more
Gastroenteritis is a major cause of hospital admissions. Learn about the current challenges to gastroenteritis diagnosis and how syndromic testing can provide a comprehensive solution.
Read more